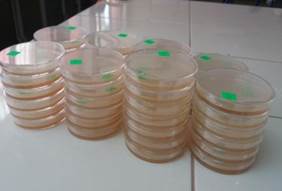
Siembra microbiol&oacute;gica.

Artículos
Efecto de Ocimum basilicum en pollos Cobb 500 sobre parámetros productivos y bacterianos
Effect of Ocimum basilicum in Cobb 500 chickens on the productive and bacterial parameters
Efecto de Ocimum basilicum en pollos Cobb 500 sobre parámetros productivos y bacterianos
Ciencia y Agricultura, vol. 19, núm. 2, pp. 13-25, 2022
Universidad Pedagógica y Tecnológica de Colombia (UPTC)
Recepción: 11 Enero 2021
Aprobación: 03 Mayo 2021
RESUMEN: La investigación se desarrolló en la Granja Santa Inés, de la Facultad de Ciencias Agropecuarias de la Universidad Técnica de Machala, el objetivo fue evaluar el efecto de la infusión de Ocimum basilicum en los pollos Cobb 500 sobre los parámetros productivos y control bacteriano. Para el experimento se aplicó un Diseño Completamente al Azar para evaluar cinco tratamientos cada uno con cuatro unidades experimentales de 10 pollos (200 aves). Los tratamientos fueron: T1, T2, T3, y T4, a los cuales se le añadió 2 ml de infusión de O. basilicum al 10%, 20%, 30% y 40% respectivamente por cada litro de agua de bebida y el T5 agua normal. Para el bienestar de las aves se empleó un manejo para naves abiertas, administrando un balanceado libre de Antibióticos Promotores de Crecimiento. Las variables evaluadas fueron: peso vivo del ave, consumo de alimento y agua acumulada, conversión alimenticia, mortalidad, microbiota bacteriana total y colimetría. Para el análisis de los datos se empleó el programa estadístico Statgraphics Centurión XV.I.®, sometiendo a las variables a un ANOVA, previo supuestos de normalidad y homogeneidad, y la prueba de Kruskal-Wallis a las que no presentaron distribución normal. Para establecer la diferencia entre las medias se usó el procedimiento de comparación múltiple de Bonferroni con un nivel del 95,0% de confianza. Los resultados concluyen que no existe un efecto en los parámetros evaluados, no presenta riesgo para la salud y que por sus propiedades biofarmacéuticas podría ser usado como una alternativa a los antibióticos sintéticos.
Palabras clave: Microbiota Bacteriano Total, UFC, Parámetros Productivos.
ABSTRACT: The research was developed at the Santa Inés Farm, of the Faculty of Agricultural Sciences of the Universidad Técnica de Machala, the objective was to evaluate the effect of the infusion of Ocimum basilicum in Cobb 500 chickens on the productive parameters and bacterial control. For the experiment, a Completely Random Design was applied to evaluate five treatments each with four experimental units of 10 chickens (200 birds). The treatments were: T1, T2, T3, and T4, to which 2 ml of infusion of O. basilicum was added at 10%, 20%, 30% and 40% respectively for each liter of drinking water and T5 normal water. For the welfare of the birds, management was used for open buildings, administering a balanced feed free of Antibiotic Growth Promoters. The variables evaluated were: live weight of the bird, consumption of feed and accumulated water, feed conversion, mortality, total bacterial microbiota and colimetry. For data analysis, the statistical program Statgraphics Centurión XV.I.® was used, subjecting the variables to an ANOVA, prior assumptions of normality and homogeneity, and the Kruskal-Wallis test for those that did not present a normal distribution. To establish the difference between the means, the Bonferroni multiple comparison procedure was used with a 95.0% confidence level. The results conclude that there is no effect on the parameters evaluated, it does not present a health risk and that due to its biopharmaceutical properties it could be used as an alternative to synthetic antibiotics.
Keywords: Colimetry, Total Bacterial Microbiota, CFU, Productive Parameters.
INTRODUCCIÓN
EL cuestionamiento actual del uso de los antibióticos promotores de crecimiento (APC) en los animales de producción ha generado expectativas debido a que favorecen factores de resistencia bacteriana al ser aplicados a niveles subterapéuticos e inclusive encontrase trazas de los mismos a nivel de la carne o subproductos (Lara et al. 2011); esto se contrapone a la creciente demanda de productos cárnicos inocuos, lo que ha llevado a buscar alternativas de reemplazo de estas sustancias químicas para mantener la eficiencia alimenticia animal (Castro, 2005)
Entre las alternativas más llamativas, se encuentra el uso de plantas medicinales, cuyos extractos y aceites han demostrado gran potencial debido a sus propiedades bactericidas, bacteriostáticas, fungicidas y virales (Lara et al. 2011). Entre ellas destaca el uso de Ocimun basilicum, más conocida como albahaca.
Según Yaldiz et al. (2018), la albahaca dulce no muestra una distribución natural, pero son cultivadas como plantas medicinales, condimentadoras u oleaginosas en cualquier parte del mundo, su cultivo se usa para producir aceite esencial, hierba culinaria, planta medicinal y para el control de insectos (Grayer et al. 1996), contiene aceite esencial de composición compleja y entre los componentes que le brindan el aroma están el 1,8-cineol, linalol, citral, metilchavicol (estragol), eugenol y metilcinamato (Lara et al. 2010).
Según Mehri et al. (2015) afirman que en los últimos años el uso de aditivos naturales como son las plantas medicinales, aceites esenciales, o extractos están ganando atención en la nutrición de aves de corral. (Karásková et al. 2015), indica que los aditivos fotogénicos presentan una alternativa plausible que mejoran una serie de procesos importantes en el cuerpo animal. Un estudio realizado por Al-Kelabi et al. (2019) manifiesta que la inclusión de la planta de albahaca dulce a la dieta mejora el rendimiento de los pollos de engorde, ya que estimula la síntesis y liberación de hormona del crecimiento. Así mismo Adaszyńska y Szczerbińska (2017), manifiesta que, una ventaja adicional de los aceites esenciales es que se pueden administrar conjuntamente con las vacunaciones debido a que el fitogénico no carga el organismo del ave; además no requiere un período de retiro antes del sacrificio, lo que garantiza la seguridad e inocuidad alimentaria. (Roldán et al. 2010) realizaron un estudio de varios aditivos fitogénicos que se utilizan para incluir en piensos, en donde determinaron los principales componentes de los aceites esenciales (Mentha spicata, Mentha piperita, Ocimum basilicum, Salvia officinalis, Rosmarinus officinalis y Thymus vulgaris) y además probaron su actividad antibacteriana sobre bacterias patógenas de: Escherichia coli, Salmonella enteritidis Salmonella typhimurium, Bacillus subtilis acidophilus y Bifidobacterium breve.
Además, en un estudio anterior, Lee et al. (2003) informan que mejoraron el rendimiento del crecimiento en pollos de engorde durante el crecimiento y fase final podría atribuirse a la presencia de aceites esenciales en la dieta, que estimulan las secreciones de enzimas digestivas endógenas, que luego mejoran digestión de nutrientes y tasa de pasaje intestinal en pollos. Por lo tanto, se necesita saber los efectos que causan el uso de Ocimum basilicum en dietas alimenticias adaptadas para pollos Cobb 500.
Según Yaldız et al. (2019) manifiesta que la albahaca dulce Ocimum basilicum es un miembro de la familia Lamiaceae, planta utilizada como aromatizantes, en aditivos de alimentos, productos farmacéuticos y cosméticos, desde la edad media se encontraba entre las plantas que servían para obtener aceites esenciales, taninos, saponinas y glucósidos, por lo que resultaba efectiva para el tratamiento de enfermedades respiratorias, urinarias y trastornos gástricos. Sam et al. (2002) la describen como una planta medicinal antihelmíntica, antibacteriana, de naturaleza antiinflamatoria, antipirética y antimicrobiana, muy eficaz para mejorar el rendimiento de los pollos de engorde y parámetros hematológicos en condición de estrés.
Según Mohamed y Abd (2020), de la planta se han aislados muchos componentes químicos entre los cuales están los flavonoides, alcaloides, taninos, terpenoides, glucósidos, saponina y ácido ascórbico; el extracto de hojas de albahaca contiene un potente antioxidante, antienvejecimiento, anticancerígeno, antiviral, también posee propiedades antimicrobianas, inmunoestimuladoras, hepatoprotectoras, inmunomoduladoras, efectos antihiperglucémicos, hipolipidémicos, antitóxicos y antiinflamatorios.
La suplementación con semillas de albahaca en las dietas para pollos de engorde aumenta significativamente los títulos de anticuerpos HI en suero contra ND e IB virus a las 6 semanas de edad (Mohamed y Abd, 2020); además, ELnaggar & El-Tahawy (2018) afirman que, la dieta con diferentes niveles de albahaca dulce, tomillo y sus aceites proporcionados a pollos de engorde aumentan significativamente proteína total, γ-globulina, globulina, IgM, IgG.
La adición de O. basilicum a la ración de pollos de engorde tiene efectos beneficiosos sobre la respuesta inmune innata que se refleja como aumentos significativos en monocitos de sangre periférica, actividad fagocítica, niveles de lisozima y órganos linfoides proporciones de peso corporal especialmente cuando se usa al 1%, pero si se usa al 0,5% podría ser más ventajoso y podría usarse en áreas con un alto riesgo de infección viral, ya que ayudará en maximizando los beneficios de las vacunas (Mohamed y Abd, 2020).
Por todo lo expuesto, se planteó el objetivo de evaluar el efecto de la infusión de Ocimum basilicum en los pollos Cobb 500 sobre los parámetros productivos y control bacteriano.
MATERIALES Y MÉTODOS
Localización de la investigación
El experimento se realizó en el galpón 1 de la Granja “Santa Inés” perteneciente a la Facultad de Ciencias Agropecuarias de la Universidad Técnica de Machala, que se encuentra ubicada en el kilómetro 5 ½ vía Machala - Pasaje. Sus coordenadas geográficas son las siguientes: longitud: 79° 54’ 05”, latitud: 3° 17’ 16”, altitud: 5 msnm y a una temperatura de 22 a 35° C.
Características de la nave
Para llevar a cabo el siguiente trabajo se adoptaron todas las normas de bioseguridad, manejo y bienestar animal, tomando en cuenta la Guía General de Carácter Voluntario, referente a la Adopción y Certificación de Buenas Prácticas Avícolas (BPA), Agrocalidad-Ecuador (2017). La nave fue adaptada para manejar 200 pollos broiler de la línea Cobb 500, para evitar las corrientes de aire y el enfriamiento interno, se acondicionaron cortinas de crianza y laterales de plástico negro en las primeras semanas de vida de las aves. Se realizó una adecuada limpieza y desinfección de la nave con una mezcla de formol aldehído y agua a razón de 400 ml de químico por cada 20 litros de agua, se flameó y caleó pisos y paredes, se desinfecto comederos, bebederos, otros materiales y la viruta de madera que serviría de cama para los pollos, todo esto con el fin de bajar la carga patógena. Como fuente de calor se instalaron focos amarillos de 100 watts en cada unidad experimental.

Figura 1
Preparación de la nave para la crianza de pollos
Preparación de la infusión y Manejo del pollo
Para la preparación de la infusión se aplicó la metodología descrita por Chiriboga et al. (2016), esta sustancia solo duraba tres días. La dosis por cada litro de agua de bebida era de 2 ml usando una jeringa identificada para cada tratamiento, esto se repitió durante todo el tiempo que se desarrolló el experimento, se les administró a los animales balanceado sin antibiótico promotor de crecimiento (APC) procedente de la fábrica de piensos “Balmar” (El Oro - Ecuador) usando todas sus etapas (pre inicial, inicial, engorde y finalizador). La investigación duró 43 días y para garantizar la sanidad de los animales se empleó un programa básico vacunal desarrollado para la zona que consistía en utilizar las vacunas de Newcastle y Gumboro.

Figura 2
Distribución de los tratamientos.
Metodología de laboratorio
Para el análisis bacteriano, se tomaron muestras fecales en todos los tratamientos con sus respectivas unidades experimentales, en los días 14, 28 y 43. Posteriormente se determinó el recuento de bacterias, cuya metodología consistió en tomar 1 gramo de heces obtenidas a partir de las deposiciones de las aves y colocadas sobre una bolsa estéril. Cada muestra fue suspendida en 9 ml de suero fisiológico estéril para obtener una dilución 1/10. Cada dilución fue sembrada en placas de Petri con agar para recuento bacteriano (Plate count agar) y Agar Macconkey para determinar Microbiota bacteriana total y Coliformes, respectivamente, a fin de establecer la menor dilución a la cual era posible hacer el recuento.
Figura 3
Siembra microbiológica.
Diseño experimental
Se empleó un Diseño Completamente al Azar (DCA), evaluando un total de 200 aves, distribuidas en 5 tratamientos, cada uno de 4 unidades experimentales (UE) de 10 pollos mixtos (40 pollos por grupo). El primer tratamiento (T1) consistió en añadir 2 ml de infusión de O. basilicum al 10% por cada litro de agua. Para el segundo tratamiento (T2), se empleó 2 ml de infusión al 20%, en el tercer tratamiento (T3) se utilizó 2 ml de infusión al 30 %, para el cuarto tratamiento (T4), 2 ml de infusión al 40% y para el tratamiento testigo (T5) se colocó agua solamente.
Variables evaluadas
Peso vivo del ave: Los pesos fueron registrados desde el día 0 hasta el día 43 (semanalmente) en cada unidad experimental, con la ayuda de una balanza electrónica (CAMRY modelo EK9332-F302), con un margen de error de ±1 g, obteniéndose 1,200 datos (5 Tratamientos x 4 Unidades Experimentales x 10 Pollos x 6 tiempos) sin descontar mortalidad. Esta variable es de tipo cuantitativa y se expresa en gramos.
Consumo de alimento acumulado: Se registró la cantidad de alimento administrado semanalmente y se descontó el sobrante en el día de pesaje de los animales, esta variable es de tipo cuantitativa y se expresa en gramos, se generaron 120 datos (5 T x 4 UE x 6 t). Aplicando la siguiente ecuación [1]:
Consumo de agua acumulada: Esta variable fue registrada semanalmente y para la obtención de los datos se usó un recipiente de volumen con medidas mínimas de 50 ml, variable de tipo cuantitativa, generándose 120 datos (5 T x 4 UE x 6 t). Aplicando la siguiente ecuación [2]:
Conversión alimenticia (C.A.): Este dato se obtuvo a partir de la división de dos variables que son el alimento consumido acumulado para la ganancia del peso de las aves. Es una variable de tipo cuantitativa, se obtuvo semanalmente, generando 120 datos (5 T x 4 UE x 6 t). Aplicando la siguiente ecuación [3]:
Mortalidad: Se registró el número de aves muertas durante todo el experimento, es una variable cuantitativa expresada en porcentaje (%), que se obtiene al contabilizar las aves que inician menos las que finalizan, por lo que se utilizó la siguiente ecuación [4]:
Microbiota bacteriana Total y Colimetria: Estas variables son de tipo cuantitativas, se expresan en Unidades Formadoras de Colonias (UFC), presentes en un gramo de heces de las aves. Se obtuvieron 120 datos (5 T x 4 UE x 2 Variables x 3 t).
Análisis estadístico
Los análisis estadísticos se realizaron según (Blasco, 2010), para ello se empleó un Diseño Completamente al Azar (DCA) realizando un ANOVA, para todas las variables estudiadas luego de aplicar supuestos de normalidad y homogeneidad, sin embargo, aquellas que no cumplieron una distribución normal, fueron sometidas a la prueba de Kruskal-Wallis. El programa estadístico utilizado fue Statgraphics Centurión XV.I.®, y para establecer la diferencia entre las medias se usó el procedimiento de comparación múltiple de Bonferroni con un nivel del 95.0% de confianza.
RESULTADOS Y DISCUSIÓN
Como se observa en la Tabla 1, al revisar la comparación la ganancia de peso vivo de los pollos en los distintos tratamientos tomando el promedio de cada semana, no existe una diferencia estadística como tal, resultados que son similares a los encontrados por (Sánchez et al., 2016) al utilizar infusiones de Cymbopogon citratus (DC.) Stapf., Plectranthus amboinicus (Lour.), Tilia cordata (Mill.), Lippia alba (Mill) y Ocimun bacilicumen el agua de bebida de pollos mixtos de la línea Cobb 500; pero difieren a los encontrados por (Lara et al., 2010), quienes al utilizar hojas de plantas aromáticas como fitoterapéuticos en 280 pollitos machos de engorda de la estirpe Ross 308 donde encontraron diferencias significativas.
En un estudio similar a los demostrados por Abbas et al., (2021), en donde compararon diferentes niveles de inclusión de aceites esenciales de albahaca y menta en el rendimiento productivo y fisiológico en dos líneas de codorniz en crecimiento, encontraron diferencias significativas demostraron que las dietas suplementadas con extractos de las plantas eran influenciadas positivamente en el consumo de alimento y tasa de conversión alimenticia.

Trat. Tratamientos: 1,2,3,4 infusión de O. basilicum al 10%, 20%, 30%, 40% respectivamente y 5 testigo o control. ᵃ: Es la representación de las diferencias estadísticas (P<0,05) encontradas al comparar con el testigo. Los datos son los promedios ± Intervalos de confianza (IC) obtenidos con la prueba de comparación múltiple de Bonferroni.
Los datos que se muestran en la Tabla 2, al ser comparados entre tratamientos y semanalmente no presentan una diferencia estadística significativa en el consumo de alimento acumulado de los pollos en cada tratamiento tomando el promedio de cada semana como tal, estos resultados son similares a los encontrados por Jahejo et al., (2019) quienes en su experimento “Efecto Inmunomodulador y promotor del crecimiento de la albahaca (Ocimum basilicum) y el Ácido ascórbico en pollos de engorde estresados por el calor” con la suplementación en la dieta de semillas de albahaca y AA, no encontraron diferencias significativas; resultados similares a los encontrados por Onwurah et al., (2011) quienes en su experiemento “Efecto de la albahaca (Ocimum basilicum L.) sobre la infección coccidial en pollos broiler” en 240 pollitos de asadero no encontraron diferencias significativas en esta variables; pero difieren a los encontrados por Lara et al., (2010), quienes encontraron diferencias a la baja en los tratamientos que llevan la combinación de harina de plantas aromáticas.

Trat. Tratamientos: 1,2,3,4 infusión de O. basilicum al 10%, 20%, 30%, 40% respectivamente y 5 testigo o control. ᵃ: Es la representación de las diferencias estadísticas (P<0,05) encontradas al comparar con el testigo. Los datos son los promedios ± Intervalos de confianza (IC) obtenidos con la prueba de comparación múltiple de Bonferroni.
En la Tabla 3, se muestra el consumo de agua acumulado por semana de los pollos en los distintos tratamientos, evidenciando que no existe una diferencia estadística como tal, resultados similares a los encontrados por Sánchez et al., (2019) quienes utilizaron una infusión de Mentha spicata L. en distintos porcentajes, en 200 pollos de engorde de la línea Cobb 500, sin obtener diferencias en esta variable evaluada. Diferente a los encontrados Jahejo et al., (2019) quienes, en su experimento con la suplementación en la dieta de semillas de albahaca y AA, manifiestan una disminución la ingesta de agua.

Trat. Tratamientos: 1,2,3,4 infusión de O. basilicum al 10%, 20%, 30%, 40% respectivamente y 5 testigo o control. ᵃ: Es la representación de las diferencias estadísticas (P<0,05) encontradas al comparar con el testigo. Los datos son los promedios ± Intervalos de confianza (IC) obtenidos con la prueba de comparación múltiple de Bonferron
Como se observa en la Tabla 4, al momento de comparar la conversión alimenticia de los pollos en cada tratamiento, los datos no presentan una diferencia estadística significativa al finalizar el experimento, resultados similares a los encontrados por Chiriboga et al., (2016) quienes al utilizar la infusión de oreganón Plectranthus amboinicus (Lour.) Spreng y del vinagre en la crianza de pollos “Acriollados” (Gallus gallusdomesticus) mejorados en 160 aves, no encontraron diferencias significativas, pero difieren a los encontrados por Jahejo et al., (2019) quienes muestran el efecto que se genera con la suplementación en la dieta de semillas de albahaca y AA, aumentando la ingesta de alimento y la eficiencia alimenticia; resultados diferentes a los encontrados por Gurbuz y Ismael (2016) quienes en su experimento “Efecto de la menta y la albahaca como aditivo alimentario en rendimiento de pollos de engorde y características de la canal” realizado en 210 pollos de un día de edad de la línea Ross 308 mostraron mayor índice de conversión al incluir el 1% y 1,5 % de la harina de albahaca; así mismo, Al-Kelabi, y Al-Kassie, (2013), quienes en su experimento “Evaluación de la planta de albahaca dulce en polvo (Ocimum basilicum L.) como aditivo alimentario, sobre el rendimiento de pollos de engorde” al emplear 300 pollos Hubbard, presentando los mejores indices de conversión aquellos que incluinan los distintos porcentajes de la planta medicinal; al igual que Onwurah et al., (2011) y Abbas et al., (2021) quienes tambien encontraron diferencias estadísticas significativas.

Trat. Tratamientos: 1,2,3,4 infusión de O. basilicum al 10%, 20%, 30%, 40% respectivamente y 5 testigo o control. ᵃᵇ: Es la representación de las diferencias estadísticas (P<0,05) encontradas al comparar con el testigo. Los datos son los promedios ± Intervalos de confianza (IC) obtenidos con la prueba de comparación múltiple de Bonferroni.
En cuanto a los resultados del análisis microbiológico (Tabla 5 y 6), al analizar los datos de Microbiota bacteriana total y colimetría al compararlos con el T5 (testigo) no se encontró una diferencia estadística significativa al finalizar el experimento, aunque se puede observar un dato aritmético de UFC en el T5, resultados que son similares a los encontrados por Sánchez et al., (2016) al utilizar infusiones de Cymbopogon citratus (DC.) Stapf., Plectranthus amboinicus (Lour.), Tilia cordata (Mill.), Lippia ALba (Mill) y Ocimun bacilicum en el agua potable de pollos mixtos de la línea Cobb 500 en donde manifiestan comparativamente que la que la colimetría realizada el día 15 después de la inoculación de E. coli mostró que había una mayor cantidad de UFC en T2 grupo (Tilo) mientras que la UFC más baja se registró con T4 en comparación con T1. En el día 28 y 43 no existió una diferencia entre los tratamientos y el testigo; difieren a los encontrados por Aguilar et al., (2020) quienes en su experimento “Actividad fitobiótica de Piper auritum y Ocimum basilicum sobre E. Coli aviar” usando 40 pollos que fueron inoculados con E.coli aviar seroptipo O2 vor vía intratraqueal mostraron el efecto positivo de administrar el extracto de albahaca al 10%.

Trat. Tratamientos: 1,2,3,4 infusión de O. basilicum al 10%, 20%, 30%, 40% respectivamente y 5 testigo o control. ᵃᵇ: Es la representación de las diferencias estadísticas (P<0,05) encontradas al comparar con el testigo. Los datos son los promedios ± Intervalos de confianza (IC) obtenidos con la prueba de comparación múltiple de Bonferroni.

Trat Tratamientos: 1,2,3,4 infusión de O. basilicum al 10%, 20%, 30%, 40% respectivamente y 5 testigo o control. ᵃᵇ: Es la representación de las diferencias estadísticas (P<0,05) encontradas al comparar con el testigo. Los datos son los promedios ± Intervalos de confianza (IC) obtenidos con la prueba de comparación múltiple de Bonferroni.
CONCLUSIONES
No existe un efecto en el incremento de peso vivo, consumo de alimento, consumo de agua, conversión alimenticia, y mortalidad en los pollos Cobb 500 al comparar los tratamientos con el testigo.
En cuanto al microbiota bacteria total y colimetría no hay un efecto estadístico significativo, pero si se observa una diferencia aritmética que posiblemente indique que a una mayor concentración se encuentre mejores resultados, lo que concordaría con los hallados de otros autores mencionados en este documento.
Por lo tanto, se asume que la infusión de O. basilicum en distintos porcentajes puede incluirse en el agua de bebida de los animales sin ningún riesgo para la salud y debido a sus propiedades biofarmaceuticas ser usado como una alternativa a los APC.
Realizar un comparativo de las infusiones, extractos puros, deshidratados, aceites esenciales para determinar la variabilidad de los principios activos y su potencial efectividad en el manejo de la producción animal.
AGRADECIMIENTO
A las autoridades de la Facultad de Ciencias Agropecuarias de la Universidad Técnica de Machala (Ecuador) por brindar los espacios para la experimentación animal
REFERENCIAS
Abbas, R. J., AlShaheen, S. A., & Majeed, T. I. (2021). Effect of Different Levels of Basil and Peppermint an Essential Oils on Productive and Physiological Performance of Two Lines of Growing Quail (Coturnix Coturnix Japonica).Biochemical and Cellular Archives, 21(1), 27-37.
Adaszyńska-Skwirzyńska, M., & Szczerbińska, D. (2017). Use of essential oils in broiler chicken production-a review.Annals of Animal Science, 17(2), 317-335.
Agrocalidad. (2017). Norma 7.5. Guía General de Carácter Voluntario, referente a la Adopción y Certificación de Buenas Prácticas Avícolas (BPA), Agrocalidad-Ecuador.Obtenido de Articulo 30 Del suministro de alimentos: De los fármacos y promotores de crecimiento en el alimen. Obtenido de https://www.agrocalidad.gob.ec/wp-content/uploads/2020/05/pecu4.pdf
Aguilar-Urquizo, E., Itza-Ortiz, M. F., Sangines-Garcia, J. R., Pineiro-Vázquez, A. T., Reyes-Ramirez, A., & Pinacho-Santana, B. (2020). Phytobiotic activity of piper auritum and ocimum basilicum on avian e. Coli.Brazilian Journal of Poultry Science,22.
Al-Kelabi, y Al-Kassie, G. (2013). Evaluation of Sweet Basil Powder Plant (Ocimum basilicum L.) as a Feed Additives, on the Performance of broilerChicks: Thair Jawad Kadhim Al-Kelabi @ and Galib M. Al-Kassie. The Iraqi Journal of Veterinary Medicine, 37(1), 52-58.
Al-Kelabi , T. J. K., Mohamed, M. F., Rezaeian, M., & Al-Karagoly, H. (2019). Growth hormone and growth hormone receptor genes expression related with productive traits of broilers under the effectiveness of the sweet basil plant additive as a growth promoter.Adv Anim Vet Sci, 7(5), 361-369.
Blasco, A. (2010). Análisis de datos experimentales. Para proyectos de fin de carrera. Valencia. Valencia: Editorial de la UPV.
Castro, M. (2005). Uso de aditivos en la alimentación de animales monogástricos.Revista Cubana de Ciencia Agrícola,39, 451-458.
Chiriboga Chuchuca, C., Sánchez Quinche, Á. R., Vargas González, O. N., Hurtado Flores, L. S., & Quevedo Guerrero, J. N. (2016). Uso de Infusión de oreganón Plectranthus amboinicus (Lour.) Spreng y del vinagre en la crianza de pollos" Acriollados"(Gallus gallus domesticus) mejorados.Acta Agronómica,65(3), 298-303.
ELnaggar, A. S., & El-Tahawy, W. S. (2018). Productive performance, physiological and immunological response of broiler chicks as affected by dietary aromatic plants and their essential oils.Egyptian Poultry Science Journal,38(3), 773-795.
Grayer, R. J., Kite, G. C., Goldstone, F. J., Bryan, S. E., Paton, A., & Putievsky, E. (1996). Infraspecific taxonomy and essential oil chemotypes in sweet basil, Ocimum basilicum.Phytochemistry,43(5), 1033-1039.
Gurbuz, Y. A. V. U. Z., & Ismael, I. A. (2016). Effect of peppermint and basil as feed additive on broiler performance and carcass characteristics.Iranian Journal of Applied Animal Science, 6(1), 149-156.
Jahejo, A. R., Rajput, N., Wen-xia, T., Naeem, M., Kalhoro, D. H., Kaka, A., ... & Jia, F. J. (2019). Immunomodulatory and growth promoting effects of basil (Ocimum basilicum) and ascorbic acid in heat stressed broiler chickens.Pakistan Journal of Zoology,51(3), 801.
Karásková, K., Suchý, P., & Straková, E. (2015). Current use of phytogenic feed additives in animal nutrition: a review.Czech J Anim Sci,60(12), 521-30.
Lara y Lara, P. E., Itzá Ortiz, M. F., Aguilar Urquiso, E., & Sanginés García, J. R. (2010). Leaf meals of aromatic plants as fitotherapeutics for broilers.Pesquisa Agropecuária Brasileira,45, 294-298.
Lee, K. W., Everts, H., Kappert, H. J., Frehner, M., Losa, R., & Beynen, A. C. (2003). Effects of dietary essential oil components on growth performance, digestive enzymes and lipid metabolism in female broiler chickens.British poultry science,44(3), 450-457.
Mehri, M., Sabaghi, V., & Bagherzadeh-Kasmani, F. (2015). Mentha piperita (peppermint) in growing Japanese quails’ diet: Serum biochemistry, meat quality, humoral immunity.Animal Feed Science and Technology,206, 57-66.
Roldán, L. P., Díaz, G. J., & Duringer, J. M. (2010). Composition and antibacterial activity of essential oils obtained from plants of the Lamiaceae family against pathogenic and beneficial bacteria.Revista Colombiana de Ciencias Pecuarias,23(4), 451-461.
Mohamed, F. H., & Abd Elaziz, N. Y. (2020). Impact of Ocimum basilicum leaves powder on immune response of chicken vaccinated against Newcastle Disease Virus.Egyptian Journal of Agricultural Research,98(2), 270-287.
Onwurah, F. B., Ojewola, G. S., & Akomas, S. (2011). Effect of basil (Ocimum Basilicum L.) on coccidial infection in broiler chicks.Academic Research International, 1(3), 438.
Sam, O., de la Luz, M., & Barroso, L. (2002). Caracterización anatómica de las hojas de la albahaca blanca (Ocimum basilicum L.).Cultivos tropicales,23(2), 39-42.
Sanchez-Quinche, A., Ávila Rivas, S. D., Hurtado Flores, L. S., Aguilar Gálvez, L. F., Vargas González, O. N., Zapata Saavedra, M. L., ... & Pérez Baena, I.(2016). Effect of Cymbopogon Citratus (DC.) Stapf., Plectra Thus Amboinicus (Lour.), Tilia Cordata (Mill.), Lippia Alba (Mill.) and Ocimun Bacilicum (L.), To Control Escherichia coli in Broiler Chickens.American International Journal of Contemporary Research, 6(5), 158-165.
Sánchez Quinche, A. R., Solórzano Saldarriaga, J. C., Quevedo Guerrero, J. N., Paladines Romero, J. R., &Pérez Baena, I . (2019). Effect of Mentha spicata L. infusion on the productive performance and organoleptic characteristics of Cobb 500 broilers.Acta Agronómica,68(4), 312-318.
Yaldiz, G., Camlica, M., & Ozen, F. (2018). Biological value and chemical components of essential oils of sweet basil (Ocimum basilicum L.) grown with organic fertilization sources.Journal of the Science of Food and Agriculture,99(4), 2005-2013.
Yaldız, G., Çamlıca, M., Özen, F., & Eratalar, S. A. (2019). Effect of poultry manure on yield and nutrient composition of sweet basil (Ocimum basilicum L.).Communications in soil science and plant analysis,50(7), 838-852.
Notas
